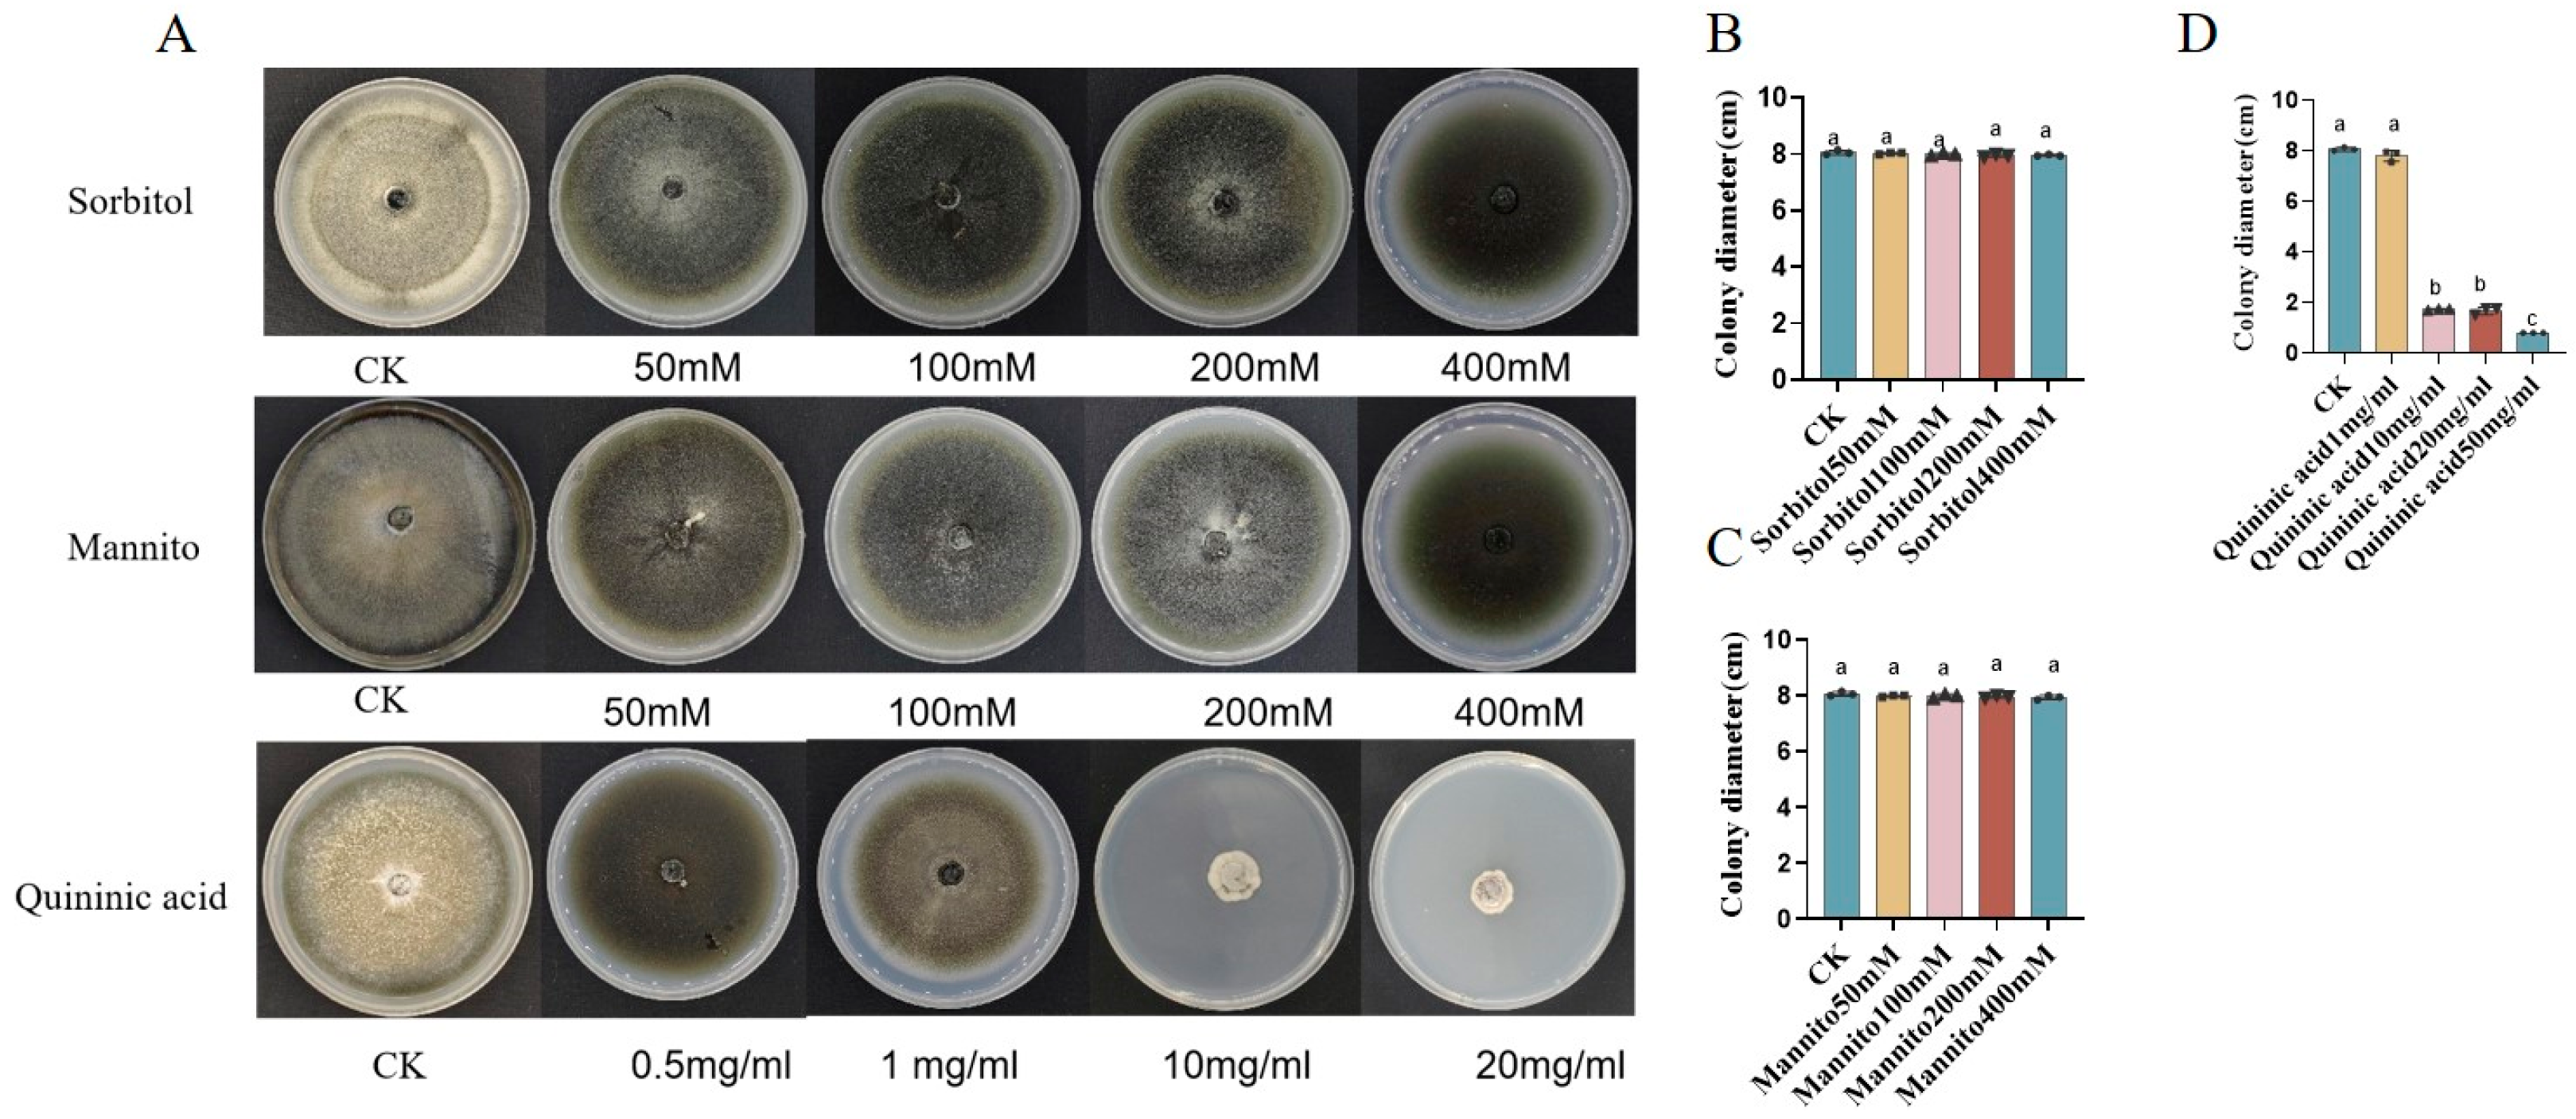
Metabolites 14 00507 g006

Rice Varieties Intercropping Induced Soil Metabolic and Microbial Recruiting to Enhance the Rice Blast (Magnaporthe Oryzae) Resistance
Abstract
1. Introduction
2. Materials and Methods
2.1. Randomized Complete Block Design (RCBD)
2.2. Disease Investigation and Soil Sample Collection
2.3. Extraction of Soil Metabolites
2.4. Quantification of Soil Metabolites by LC-MS/MS
2.5. Differential Analysis of Soil Metabolites
2.6. Genomic DNA Extraction and PCR Amplification of Rhizosphere Soil
2.7. Data Optimization of Soil Microbes
2.8. OTU Clustering
2.9. Differential Analysis of Soil Microbial Communities
2.10. KEGG Annotation and Enrichment Analysis
2.11. Correlation and Statistical Analysis
2.12. The Rice Blast Control Effects of Three Significantly Correlated Metabolites
3. Results
3.1. Rice Intercropping Significantly Reduced the Occurrence of Rice Blast
3.2. Soil Resistance-Related Enzyme Activity in the Rice Intercropping System
3.3. Soil Metabolites Detected by LC-MS/MS in Rice Intercropping System
3.4. Differential Metabolites in Rice Intercropping System
3.5. The Metabolomic Pathway in Rice Intercropping System Annotated by KEGG
3.6. Intercropping System Regulates the Assembly of Rhizosphere Bacterial Community
3.7. Beneficial Microorganisms Were Significantly Related to the Evolved Soil Metabolites
3.8. Correlated Metabolites Have Significant Control Effects on Rice Blast
4. Discussion
5. Conclusions
Supplementary Materials
Author Contributions
Funding
Institutional Review Board Statement
Informed Consent Statement
Data Availability Statement
Acknowledgments
Conflicts of Interest
References
- Liu, Q.; Yang, J.; Ahmed, W.; Wan, X.; Wei, L.; Ji, G.J. Exploiting the antibacterial mechanism of phenazine substances from Lysobacter antibioticus 13-6 against Xanthomonas oryzae pv. oryzicola. J. Microbiol. 2022, 60, 496–510. [Google Scholar] [CrossRef] [PubMed]
- Simkhada, K.; Thapa, R. Rice Blast, A Major Threat to the Rice Production and its Various Management Techniques. Turk. J. Agric. Food Sci. Technol. 2022, 10, 147–157. [Google Scholar] [CrossRef]
- Li, Y.; Xu, L.; Letuma, P.; Lin, W. Metabolite profiling of rhizosphere soil of different allelopathic potential rice accessions. BMC Plant Biol. 2020, 20, 265. [Google Scholar] [CrossRef] [PubMed]
- Sahu, P.K.; Sao, R.; Choudhary, D.K.; Thada, A.; Kumar, V.; Mondal, S.; Das, B.K.; Jankuloski, L.; Sharma, D. Advancement in the Breeding, Biotechnological and Genomic Tools towards Development of Durable Genetic Resistance against the Rice Blast Disease. Plants 2022, 11, 2386. [Google Scholar] [CrossRef]
- Zhu, Y.Y.; Fang, H.; Wang, Y.Y.; Fan, J.X.; Yang, S.S.; Wah, M.; Mundt, C.C. Panicle blast and canopy moisture in rice cultivar mixtures. Phytopathology 2005, 95, 433–438. [Google Scholar] [CrossRef]
- Fau, P.F.; Fau, C.G.; Fau, F.G.; Andrivon, D. Protection of susceptible potato cultivars against late blight in mixtures increases with decreasing disease pressure. Phytopathology 2006, 96, 777–783. [Google Scholar] [CrossRef]
- Kristoffersen, R.; Eriksen, L.; Nielsen, G.C.; Jørgensen, J.R.; Jørgensen, L.N. Management of Septoria Tritici Blotch Using Cultivar Mixtures. Plant Dis. 2022, 106, 1341–1349. [Google Scholar] [CrossRef]
- Han, G.-Y.; Lang, J.; Sun, Y.; Wang, Y.-Y.; Zhu, Y.-Y.; Lu, B.-R. Intercropping of rice varieties increases the efficiency of blast control through reduced disease occurrence and variability. J. Integr. Agric. 2016, 15, 795–802. [Google Scholar] [CrossRef]
- Van Bruggen, A.H.; Finckh, M.R. Plant Diseases and Management Approaches in Organic Farming Systems. Annu. Rev. Phytopathol. 2016, 54, 25–54. [Google Scholar] [CrossRef]
- Ratnadass, A.; Fernandes, P.; Avelino, J.; Habib, R. Plant species diversity for sustainable management of crop pests and diseases in agroecosystems: A review. Agron. Sustain. Dev. 2011, 32, 273–303. [Google Scholar] [CrossRef]
- Qin, J.; He, H.; Luo, S.; Li, H. Effects of rice-water chestnut intercropping on rice sheath blight and rice blast diseases. Crop Prot. 2013, 43, 89–93. [Google Scholar] [CrossRef]
- Zhu, S.S.; Morel, J.B. Molecular Mechanisms Underlying Microbial Disease Control in Intercropping. Mol. Plant Microbe Interact. 2019, 32, 20–24. [Google Scholar] [CrossRef] [PubMed]
- Ning, C.; Qu, J.; He, L.; Yang, R.; Chen, Q.; Luo, S.; Cai, K. Improvement of yield, pest control and Si nutrition of rice by rice-water spinach intercropping. Field Crops Res. 2017, 208, 34–43. [Google Scholar] [CrossRef]
- He, P.; Wang, C.; Zhang, N.; Liu, B.; Yang, Y.; Zhu, Y.; Li, X.; Yu, X.; Han, G.; Wang, Y.-Y. Multi-genotype varieties reduce rice diseases through enhanced genetic diversity and show stability and adaptability in the field. Phytopathol. Res. 2021, 3, 28. [Google Scholar] [CrossRef]
- Bai, B.; Liu, W.; Qiu, X.; Zhang, J.; Zhang, J.; Bai, Y. The root microbiome: Community assembly and its contributions to plant fitness. J. Integr. Plant Biol. 2022, 64, 230–243. [Google Scholar] [CrossRef]
- Pelissier, R.; Violle, C.; Morel, J.B. Plant immunity: Good fences make good neighbors? Curr. Opin. Plant Biol. 2021, 62, 102045. [Google Scholar] [CrossRef]
- Ahmed, W.; Dai, Z.; Zhang, J.; Li, S.; Ahmed, A.; Munir, S.; Liu, Q.; Tan, Y.; Ji, G.; Zhao, Z.J.M.S. Plant-microbe interaction: Mining the impact of native Bacillus amyloliquefaciens WS-10 on tobacco bacterial wilt disease and rhizosphere microbial communities. Microbiol. Spectr. 2022, 10, e01471-22. [Google Scholar] [CrossRef]
- Wang, G.; Li, X.; Xi, X.; Cong, W.-F. Crop diversification reinforces soil microbiome functions and soil health. Plant Soil. 2022, 476, 375–383. [Google Scholar] [CrossRef]
- Li, C.; Ahmed, W.; Li, D.; Yu, L.; Xu, L.; Xu, T.; Zhao, Z.J.A.S.E. Biochar suppresses bacterial wilt disease of flue-cured tobacco by improving soil health and functional diversity of rhizosphere microorganisms. Appl. Soil. Ecol. 2022, 171, 104314. [Google Scholar] [CrossRef]
- Zhao, X.; Dong, Q.; Han, Y.; Zhang, K.; Shi, X.; Yang, X.; Yuan, Y.; Zhou, D.; Wang, K.; Wang, X.; et al. Maize/peanut intercropping improves nutrient uptake of side-row maize and system microbial community diversity. BMC Microbiol. 2022, 22, 14. [Google Scholar] [CrossRef]
- Wu, H.; Lin, M.; Rensing, C.; Qin, X.; Zhang, S.; Chen, J.; Wu, L.; Zhao, Y.; Lin, S.; Lin, W. Plant-mediated rhizospheric interactions in intraspecific intercropping alleviate the replanting disease of Radix pseudostellariae. Plant Soil. 2020, 454, 411–430. [Google Scholar] [CrossRef]
- Chang, X.; Yan, L.; Naeem, M.; Khaskheli, M.I.; Zhang, H.; Gong, G.; Zhang, M.; Song, C.; Yang, W.; Liu, T.; et al. Maize/Soybean Relay Strip Intercropping Reduces the Occurrence of Fusarium Root Rot and Changes the Diversity of the Pathogenic Fusarium Species. Pathogens 2020, 9, 211. [Google Scholar] [CrossRef] [PubMed]
- Wang, N.Q.; Kong, C.H.; Wang, P.; Meiners, S.J. Root exudate signals in plant-plant interactions. Plant Cell Env. 2021, 44, 1044–1058. [Google Scholar] [CrossRef] [PubMed]
- McRose, D.L.; Li, J.; Newman, D.K. The chemical ecology of coumarins and phenazines affects iron acquisition by pseudomonads. Proc. Natl. Acad. Sci. USA 2023, 120, e2217951120. [Google Scholar] [CrossRef] [PubMed]
- Chen, Y.; Bonkowski, M.; Shen, Y.; Griffiths, B.S.; Jiang, Y.; Wang, X.; Sun, B. Root ethylene mediates rhizosphere microbial community reconstruction when chemically detecting cyanide produced by neighbouring plants. Microbiome 2020, 8, 4. [Google Scholar] [CrossRef]
- Zhou, X.; Zhang, J.; Khashi, U.R.M.; Gao, D.; Wei, Z.; Wu, F.; Dini-Andreote, F. Interspecific plant interaction via root exudates structures the disease suppressiveness of rhizosphere microbiomes. Mol. Plant 2023, 16, 849–864. [Google Scholar] [CrossRef]
- Ren, L.; Huo, H.; Zhang, F.; Hao, W.; Xiao, L.; Dong, C.; Xu, G. The components of rice and watermelon root exudates and their effects on pathogenic fungus and watermelon defense. Plant Signal. Behav. 2016, 11, e1187357. [Google Scholar] [CrossRef]
- Hu, L.; Robert, C.A.M.; Cadot, S.; Zhang, X.; Ye, M.; Li, B.; Manzo, D.; Chervet, N.; Steinger, T.; van der Heijden, M.G.A.; et al. Root exudate metabolites drive plant-soil feedbacks on growth and defense by shaping the rhizosphere microbiota. Nat. Commun. 2018, 9, 2738. [Google Scholar] [CrossRef]
- Zhang, J.; Wei, L.; Yang, J.; Ahmed, W.; Wang, Y.; Fu, L.; Ji, G.J.F.i.m. Probiotic consortia: Reshaping the rhizospheric microbiome and its role in suppressing root-rot disease of Panax notoginseng. Front. Microbiol. 2020, 11, 701. [Google Scholar] [CrossRef]
- Chen, S.; Zhou, Y.; Chen, Y.; Gu, J. fastp: An ultra-fast all-in-one FASTQ preprocessor. Bioinformatics 2018, 34, i884–i890. [Google Scholar] [CrossRef]
- Magoč, T.; Salzberg, S.L. FLASH: Fast length adjustment of short reads to improve genome assemblies. Bioinformatics 2011, 27, 2957–2963. [Google Scholar] [CrossRef] [PubMed]
- Edgar, R.C. UPARSE: Highly accurate OTU sequences from microbial amplicon reads. Nat. Methods 2013, 10, 996–998. [Google Scholar] [CrossRef] [PubMed]
- Stackebrandt, E.; Goebel, B.M. Taxonomic note: A Place for DNA-DNA Reassociation and 16s rrna sequence analysis in the present species definition in bacteriology. Int. J. Syst. Bacteriolo. 1994, 44, 846–849. [Google Scholar] [CrossRef]
- Kamennaya, N.A.; Gray, J.; Ito, S.; Kainuma, M.; Nguyen, M.V.; Khilyas, I.V.; Birarda, G.; Bernie, F.; Hunt, M.; Vasadia, D.; et al. Deconstruction of plant biomass by a Cellulomonas strain isolated from an ultra-basic (lignin-stripping) spring. Arch. Microbiol. 2020, 202, 1077–1084. [Google Scholar] [CrossRef]
- Nelson, R.; Wiesner-Hanks, T.; Wisser, R.; Balint-Kurti, P. Navigating complexity to breed disease-resistant crops. Nat. Rev. Genet. 2018, 19, 21–33. [Google Scholar] [CrossRef]
- Raboin, L.-M.; Randriambololona, T.; Radanielina, T.; Ramanantsoanirina, A.; Ahmadi, N.; Dusserre, J. Upland rice varieties for smallholder farming in the cold conditions in Madagascar’s tropical highlands. Field Crops Res. 2014, 169, 11–20. [Google Scholar] [CrossRef]
- Wang, Z.-g.; Bao, X.-g.; Li, X.-f.; Jin, X.; Zhao, J.-h.; Sun, J.-h.; Christie, P.; Li, L. Intercropping maintains soil fertility in terms of chemical properties and enzyme activities on a timescale of one decade. Plant Soil. 2015, 391, 265–282. [Google Scholar] [CrossRef]
- Li, X.; Qu, C.; Bian, Y.; Gu, C.; Jiang, X.; Song, Y. New insights into the responses of soil microorganisms to polycyclic aromatic hydrocarbon stress by combining enzyme activity and sequencing analysis with metabolomics. Environ. Pollut. 2019, 255, 113312. [Google Scholar] [CrossRef]
- Lambers, H.; Raven, J.A.; Shaver, G.R.; Smith, S.E. Plant nutrient-acquisition strategies change with soil age. Trends Ecol. Evol. 2008, 23, 95–103. [Google Scholar] [CrossRef]
- Richards, R.A. Selectable traits to increase crop photosynthesis and yield of grain crops. J. Exp. Bot. 2000, 51, 447–458. [Google Scholar] [CrossRef]
- Malobane, M.E.; Nciizah, A.D.; Nyambo, P.; Mudau, F.N.; Wakindiki, I.I.C. Microbial biomass carbon and enzyme activities as influenced by tillage, crop rotation and residue management in a sweet sorghum cropping system in marginal soils of South Africa. Heliyon 2020, 6, e05513. [Google Scholar] [CrossRef] [PubMed]
- Mommer, L.; Kirkegaard, J.; van Ruijven, J. Root–Root Interactions: Towards A Rhizosphere Framework. Trends Plant Sci. 2016, 21, 209–217. [Google Scholar] [CrossRef] [PubMed]
- Xiong, H.; Kakei, Y.; Kobayashi, T.; Guo, X.; Nakazono, M.; Takahashi, H.; Nakanishi, H.; Shen, H.; Zhang, F.; Nishizawa, N.K.; et al. Molecular evidence for phytosiderophore-induced improvement of iron nutrition of peanut intercropped with maize in calcareous soil. Plant Cell Environ. 2013, 36, 1888–1902. [Google Scholar] [CrossRef] [PubMed]
- Hazrati, H.; Fomsgaard, I.S.; Kudsk, P. Targeted metabolomics unveil alteration in accumulation and root exudation of flavonoids as a response to interspecific competition. J. Plant Interact. 2021, 16, 53–63. [Google Scholar] [CrossRef]
- Leoni, F.; Hazrati, H.; Fomsgaard, I.S.; Moonen, A.C.; Kudsk, P. Determination of the Effect of Co-cultivation on the Production and Root Exudation of Flavonoids in Four Legume Species Using LC-MS/MS Analysis. J. Agric. Food Chem. 2021, 69, 9208–9219. [Google Scholar] [CrossRef]
- Tang, W.-Q.; Zhang, W.-L.; Zhu, X.-Q.; Dong, B.-Z.; Li, Y.-C.; Yang, N.; Zhang, Y.; Wang, Y.-Y.; Han, G.-Y. Effects of diverse mixture intercropping on the structure and function of bacterial communities in rice rhizosphere. Acta Agron. Sin. 2023, 49, 1111–1121. [Google Scholar]
- Bulgarelli, D.; Schlaeppi, K.; Spaepen, S.; Ver Loren van Themaat, E.; Schulze-Lefert, P. Structure and functions of the bacterial microbiota of plants. Annu. Rev. Plant Biol. 2013, 64, 807–838. [Google Scholar] [CrossRef]
- Li, X.; Panke-Buisse, K.; Yao, X.; Coleman-Derr, D.; Ding, C.; Wang, X.; Ruan, H. Peanut plant growth was altered by monocropping-associated microbial enrichment of rhizosphere microbiome. Plant Soil. 2019, 446, 655–669. [Google Scholar] [CrossRef]
- Stuttmann, J.; Hubberten, H.M.; Rietz, S.; Kaur, J.; Muskett, P.; Guerois, R.; Bednarek, P.; Hoefgen, R.; Parker, J.E. Perturbation of Arabidopsis amino acid metabolism causes incompatibility with the adapted biotrophic pathogen Hyaloperonospora arabidopsidis. Plant Cell. 2011, 23, 2788–2803. [Google Scholar] [CrossRef]
- Zhao, X.Y.; Qi, C.H.; Jiang, H.; Zhong, M.S.; Zhao, Q.; You, C.X.; Li, Y.Y.; Hao, Y.J. MdWRKY46-Enhanced Apple Resistance to Botryosphaeria dothidea by Activating the Expression of MdPBS3.1 in the Salicylic Acid Signaling Pathway. Mol. Plant-Microbe Interact. MPMI 2019, 32, 1391–1401. [Google Scholar] [CrossRef]
- Spadaro, D.; Ciavorella, A.; Dianpeng, Z.; Garibaldi, A.; Gullino, M.L. Effect of culture media and pH on the biomass production and biocontrol efficacy of a Metschnikowia pulcherrima strain to be used as a biofungicide for postharvest disease control. Can. J. Microbiol. 2010, 56, 128–137. [Google Scholar] [CrossRef]
- Xu, F.; Valappil, A.K.; Zheng, S.; Zheng, B.; Yang, D.; Wang, Q. 3,5-DCQA as a Major Molecule in MeJA-Treated Dendropanax morbifera Adventitious Root to Promote Anti-Lung Cancer and Anti-Inflammatory Activities. Biomolecules 2024, 14, 705. [Google Scholar] [CrossRef]

Disclaimer/Publisher’s Note: The statements, opinions and data contained in all publications are solely those of the individual author(s) and contributor(s) and not of MDPI and/or the editor(s). MDPI and/or the editor(s) disclaim responsibility for any injury to people or property resulting from any ideas, methods, instructions or products referred to in the content. |
© 2024 by the authors. Licensee MDPI, Basel, Switzerland. This article is an open access article distributed under the terms and conditions of the Creative Commons Attribution (CC BY) license (https://creativecommons.org/licenses/by/4.0/).
Share and Cite
Zhu, X.-Q.; Li, M.; Li, R.-P.; Tang, W.-Q.; Wang, Y.-Y.; Fei, X.; He, P.; Han, G.-Y. Rice Varieties Intercropping Induced Soil Metabolic and Microbial Recruiting to Enhance the Rice Blast (Magnaporthe Oryzae) Resistance. Metabolites 2024, 14, 507. https://doi.org/10.3390/metabo14090507
Zhu X-Q, Li M, Li R-P, Tang W-Q, Wang Y-Y, Fei X, He P, Han G-Y. Rice Varieties Intercropping Induced Soil Metabolic and Microbial Recruiting to Enhance the Rice Blast (Magnaporthe Oryzae) Resistance. Metabolites. 2024; 14(9):507. https://doi.org/10.3390/metabo14090507
Chicago/Turabian StyleZhu, Xiao-Qiao, Mei Li, Rong-Ping Li, Wen-Qiang Tang, Yun-Yue Wang, Xiao Fei, Ping He, and Guang-Yu Han. 2024. "Rice Varieties Intercropping Induced Soil Metabolic and Microbial Recruiting to Enhance the Rice Blast (Magnaporthe Oryzae) Resistance" Metabolites 14, no. 9: 507. https://doi.org/10.3390/metabo14090507
APA StyleZhu, X.-Q., Li, M., Li, R.-P., Tang, W.-Q., Wang, Y.-Y., Fei, X., He, P., & Han, G.-Y. (2024). Rice Varieties Intercropping Induced Soil Metabolic and Microbial Recruiting to Enhance the Rice Blast (Magnaporthe Oryzae) Resistance. Metabolites, 14(9), 507. https://doi.org/10.3390/metabo14090507

